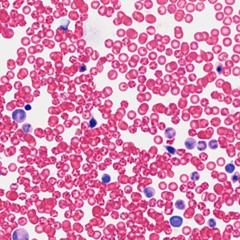
Bitemarks II

England
Alex Rushfirth
244
2:53
Sep 27, 2022
1
1
England where are we
Twenty-first century
Hyacinth comedy
Alien marry me
Why don’t we go to school again
Why don’t we break for lunch
Why don’t we take the day off
Why don’t we just start again
England football team
W…